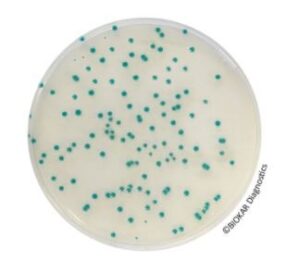
RHAPSODY supplement

RHAPSODY supplement
$0.00
Manufacturer: Biokar Diagnostics
CAT NO: BS08908
- Description
- Size Guide
- Vendor Info
- More Products
Description
RHAPSODY supplement
Product Description of RHAPSODY supplement
RHAPSODY Agar® is a selective medium used for the enumeration of Pseudomonas spp. in food products and environmental samples.
This method is officially certified by AFNOR Certification for the enumeration of presumptive Pseudomonas spp. in meat products, in comparison to the reference method NF EN ISO 13720 : 2010, under the reference number BKR 23/09-05/15 A and in dairy products, in comparison to the reference method XP ISO/TS 11059 : 2009, under the reference number BKR 23/0905/15 B.
PACKAGING
Pre-poured medium:
BM16708 – 20 Petri plates Ø 90 mm
Dehydrated base medium:
BK214HA – 500 g bottle
RHAPSODY Selective Supplement:
BS08908 – 10 vials qsp 500 mL